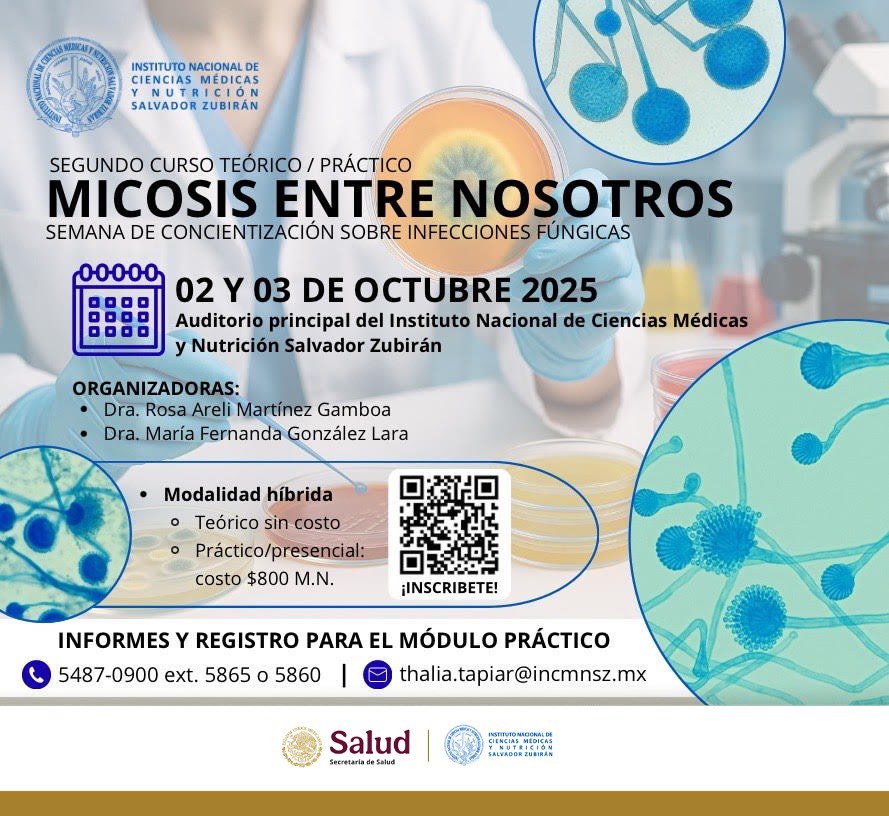
Fer Gonzalez Lara tweet media

Sabitlenmiş Tweet
Fer Gonzalez Lara
4.3K posts


Fer Gonzalez Lara
@ferduende
duende en CDMX / Infectious Diseases / Clinical Micro Lab 🇲🇽🍄🏳️🌈🙎🏼
Mexico City Katılım Temmuz 2010
1.1K Takip Edilen4.6K Takipçiler
Fer Gonzalez Lara retweetledi

Hoy (24/Mar) es el Día Mundial de la Tuberculosis, y en Hipócrates 2.0 no pasará desapercibido.
Platicaré con @ferduende sobre este problema de salud desde una perspectiva integral: situación epidemiológica global y en México, retos clínicos para diagnóstico oportuno, determinantes sociales que sostienen la transmisión, prevención efectiva (vacunación, tamizaje, contactos), el desafío de la TB farmacorresistente y cómo comunicar sin estigma.
La tuberculosis no es del pasado. Es un problema vigente de salud pública y un tema urgente de equidad.
Ya saben, a las 18 hrs (CDMX) por @RadioUNAM 96.1 FM, y en el streaming de por acá 👇🏽
radio.unam.mx/streaming/Radi…
También en el canal de Youtube del @UNAMPUIREE
@UNAMPUIREE" target="_blank" rel="nofollow noopener">youtube.com/@UNAMPUIREE

Español

@ferduende fer, alguien en facebook encontró tu INE y te localicé por acá
Español

Los programas de optimización de diagnóstico microbiológico (PRODIM) son pieza clave de los PROA
#SemanaMundialRAM
#WorldAMRAwarenessWeek



Español
Fer Gonzalez Lara retweetledi

Dra Constanza Taverna, del Hospital Malbran, sobre el diagnóstico de levaduras por MALDI-TOF y la amplia experiencia de la RENAEM
🤩🤩
Curso Micosis Entre Nosotros @incmnszmx



Español

Fotaza!!!! Dos grandes amigos, dos grandes maestros a quienes admiro profundamente 🙌🏼🙌🏼🙌🏼.
Fer Gonzalez Lara@ferduende
Una foto muy significativa. Compartir aula con el maestro admirado desde pregrado, posgrado y ahora la vida real. Con un grupo especial, de los que motivan a seguir dando clases.
Español
Fer Gonzalez Lara retweetledi

* * * CURSO * * *
Segundo Curso Teórico / Práctico
MICOSIS ENTRE NOSOTROS
2 y 3 de octubre
Inscripción: docs.google.com/forms/d/e/1FAI…

Español

No se pierdan la segunda edición del curso “Micosis entre Nosotros” en el @incmnszmx
Save the Date!
#FungiFriday #thinkfungus

Español
Fer Gonzalez Lara retweetledi
Fer Gonzalez Lara retweetledi

El Dr. Alejandro Ramírez Del Val, junto con el equipo de trasplante del INCMNSZ, realizó con éxito el primer trasplante simultáneo de riñón y páncreas. Este importante logro fue posible gracias al trabajo de un gran equipo multidisciplinario. @alejandrordv @SSalud_mx

Español
Fer Gonzalez Lara retweetledi

#ComunicadoSalud
Secretaría de Salud informa la detección del primer caso humano de influenza aviar A (H5N1)
➡️ bit.ly/41XnNa7

Español
Fer Gonzalez Lara retweetledi

Among our most-read in 2024 ⤵️
A global study in @TheLancetPH reveals stark differences in major causes of disease burden between females and males. Findings underscore the need for gender-responsive approaches to health.
Read more: hubs.li/Q030zvyg0

English
Fer Gonzalez Lara retweetledi

Dime que hay en tus aguas residuales y…
ASM@ASMicrobiology
Wastewater monitoring serves as an early detection system for outbreaks, allowing public health officials to better understand and respond to public health threats. See why wastewater surveillance is an essential tool for protecting public health: asm.social/2b2
Español
Fer Gonzalez Lara retweetledi












